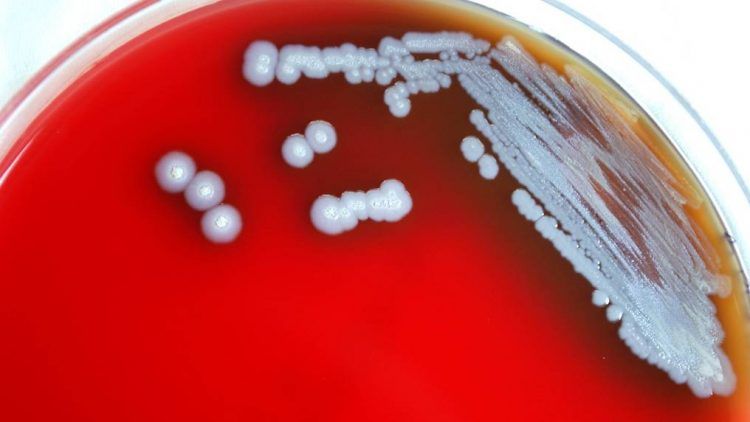
Alerta sanitaria sobre bacteria de enfermedad rara en Misisipi

Los Centros para el Control junto a la Prevención de Enfermedades (CDC) de Estados Unidos emitieron una alerta sanitaria a los médicos luego de descubrir una bacteria que está detrás de una enfermedad rara en Misisipi.
La bacteria fue encontrada por primera vez en el territorio continental del país y dentro de ser rara también es evaluada como grave.
A raíz de la investigación, debido a dos casos de melioidosis humana, se detectó la bacteria Burkholderia pseudomallei (B. pseudomallei) en muestras de suelo y agua de charcos de la región de la Costa del Golfo del sur de Misisipi.
Ver: Suman 14 mil los casos confirmados de viruela del mono
Las dos personas, no emparentadas, vivían muy cerca geográficamente y se contagiaron con dos años de diferencia, en 2020 y en 2022.
Esto llevó a las autoridades sanitarias a investigar los productos domésticos y el entorno de sus casas.
La melioidosis provoca fiebre, dolor articular y cefaleas, así como neumonía, formación de abscesos e infecciones sanguíneas.
En Estados Unidos se producen de media unos 12 casos al año, la mayoría relacionados con viajes a regiones tropicales y subtropicales, donde la bacteria es endémica.
Un grupo de 2021 que incluía a cuatro personas de cuatro estados estaba relacionado con un spray de aromaterapia contaminado de importación.
La melioidosis
Es una infección causada por la bacteria gramnegativa Burkholderia (antes denominado Pseudomonas) pseudomallei.
Sus manifestaciones incluyen neumonía, septicemia e infección localizada de varios órganos.
El diagnóstico se establece por tinción y cultivo.
El tratamiento con antibióticos, como ceftazidima, es prolongado.